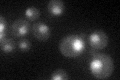
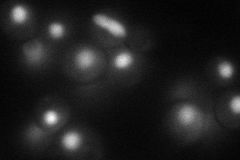
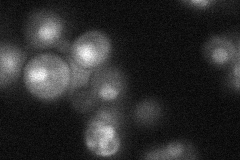
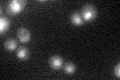

View description
Protein required for pre-mRNA splicing; associates with the spliceosome and interacts with splicing factors Prp22p and Prp46p; orthologous to human transcriptional coactivator SKIP and can activate transcription of a reporter gene
Localization:
Intensity:
Fold change:
Significance:
-
C’ GFP library in SD
nucleus26.92 -
N' NOP1pr-GFP in SD
nucleus57.573 -
N' TEF2pr-mCherry in SD

nucleus41.832 -
N' NATIVEpr-GFP in SD
nucleus29.1959 -
N' TEF2pr-VC and Cyto-VN in SD

#N/A0 -
C’ GFP library in SD+DTT

nucleus26.860.99No -
C’ GFP library in SD+H2O2

nucleus34.291.27No -
C’ GFP library in Starvation Media
nucleus45.831.7Yes -
C’ GFP library on the background of Pup2-DaMP

nucleus -
C’ GFP library on the background of CCT mutant

nucleus30.67331.13939No
